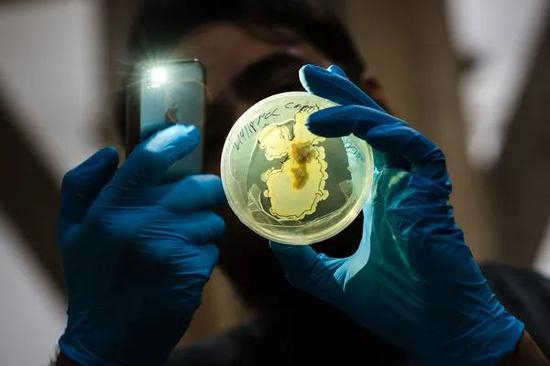
▲ 图片来自：NYTimes

作者:吴志奇
青春药、益智药、生化眼、数字纹身、磁体感知、性永动机。。。。。。
听起来很科幻,但这群人——生物黑客,把它们变成了现实。
3 月 24 日,美国《THE WEEK》周刊刊登了《人类长寿奥秘会被破解吗?》的文章,里面一群哈佛医学院的生物黑客,认为他们通过操纵一种跟血管生长相关的基因,能让人类接近“长生不老”的秘密。
鉴于基因编辑、纳米技术和机器人技术的快速进步,一些未来学家预计,这一代生物黑客将使人类的寿命延长一倍,衰老不过像其他疾病一样治愈就好了。

这只是生物黑客们探索的方向之一。
他们认为,戴眼镜、助听器、义肢都只是协助正常能力,而超越肉体局限,才是人类未来。
也许你身边还没有生物黑客,但作为整个科技领域最强大、发展最快的一个分支,他们将在不远的未来掀起巨浪。
那么生物黑客,到底是怎样一种神秘存在?
是“科学怪人”也是“科学圣斗士”
所谓生物黑客(Biohacker),简单来说,就是用科技“黑”进人体,突破身体限制。

作为今天活跃的最令人兴奋的亚文化之一,“生物黑客”一词早于 1988 年出现于《华盛顿邮报》一篇文章。在第一波互联网兴起之时,他们比电脑黑客更大胆、前沿、触及禁忌,用自己身体进行各种基于基因学、生物学和医学的实验研究。
而在早期,生物黑客的实验其实就等于是可穿戴设备的升级,只是将“体外穿戴”变成了更便捷的“体内植入”。
当时,雷丁大学控制论系(控制论:关于在动物和机器中控制和通讯的科学)教授 Kevin Warwick,成了第一个试验植入物——射频识别装置(RFID)的人,他训练有素的能力和科学成果让生物黑客引起了主流媒体关注。

▲ 图片来自:CNN
最开始,他打个响指就能打开照明系统,后来,他将更多传感器都植入手臂以延伸身体功能,甚至尝试过将妻子手心植入装置,这样在大西洋彼岸,他也能感受到人们握住她妻子的手的感觉。
在结合人和机器的路上,Warwick 开了一个先锋。

另一位最具戏剧性的生物黑客就是 DIY 朋克的代表人物 Lepht Anonym,在没有任何学术机构的支持或医生团队帮助下,她自己将金属和机器植入了肉体。
Anonym 声称“一个土豆削皮器和一瓶伏特加就可以搞定一切”。
她在自己公寓里用伏特加对针头、手术刀或削皮器消毒,然后进行身体实验。Anonym 曾在皮肤下放入微小的磁铁和电子设备,让自己能随时感应到方向和磁场变化,想象一下——就像在街上盯着手机屏幕走路也能感知周遭一切环境,就像一只鸟闭着眼睛就能在世界航行。

▲ Lepht Anonym
后来 Anonym 还尝试了植入了各类传感器,她也因此成为很多生物黑客的模仿对象和灵感来源。
他们通过体内植入无线通讯(NFC)晶片、LED 灯、磁石等,从而捕捉声纳、紫外线、Wi-Fi 和热量数据等肉眼不可见的信息。

▲ 机器人艺术家 ManelMuñoz 在他的身体中安装了一个大气感觉器官,能通过耳朵中的振动感受大气变化
“体内植入”也已经不止填补人类缺陷,更成了人类新的感官延伸。
英国艺术家 Neil Harbisson 就因为在头顶“插”了一根感官天线,也让它成了最令人难忘的生物黑客之一。
起源是因为他天生色盲,因此通过天线的内置摄像头将颜色转换成能听的声波,后来,他不仅可以识别 360 种颜色,还能看到了一些鸟类和昆虫才能看到的紫外线,和蛇才能感应到的红外线。

▲Neil Harbisson
过去几年里,已经有数以千计的瑞典人把米粒大小的 RFID 植入手臂中。他们用千元左右的成本,就能用这种设备取代钥匙、密码和电子票等,给门、电脑和各种电子设备“开锁”。

渐渐地,生物黑客开始形成松散的文化,主要通过 biohack.me 等在线论坛进行连接,有相同想法的人们聚集在一起交换最新的创意,在“黑”进人体系统这条路上乐此不疲。
一名叫 Rich Lee 的生物黑客,就将一块拇指大小的马达植入生殖器的脂肪层下。这块被称作 Lovetron 9000 的装置由马达、电池和开关组成,开关一启动就能持续震动。持续多久?由自己控制。有多厉害?Rich Lee 表示:
它能将我的性能力从犹他州男性的平均水准,拔高到半兽人级别。

▲ Rich Lee
但看上去猎奇的行为,其实也只是一群对科学技术有着强烈探索欲的人,希望凭自己能力也能使用生物技术,小则改善自身需求,大则改变社会现状。
现在,生物黑客圈也形成了 Genspace 、DIYbio 、 Grindhouse Wetwares 等知名团体,单单美国的生物黑客运动企业家和业余爱好者就数以万计,每年很多人都还会在奥斯汀(美国得克萨斯州首府)召开大会进行资源共享。
生物黑客也被分为了营养基因组学、实验生物学、技术增强和 Grinder 生化改造等四大类别,人体改造也有了更多新的可能性。

他们有的只是通过另类饮食和生活习惯保持健康,如硅谷著名养生黑客 Dave Asprey——也是防弹咖啡创始人,每六个月给自己注射一次自己的干细胞,每天服用 100 片补充剂,在红外线下沐浴,在高压氧气室里闲逛,以此达到活到 180 岁的目标。

▲ Dave Asprey
有的则试图通过科技突破人类身体极限,如上文所述,他们热衷于把各式各样的电子器材植入自己身体作试验。
还有生物黑客圈里争议系数最高的基因改造——大部分涉猎这块的生物黑客只是为了增强自身或治愈难疾,但却数次引起巨大的舆论风波。
加上大部分公众其实对生物黑客运动并不了解,这个充满神秘感的群体,似乎永远也无法摆脱安全和死亡交织的风险。
▲ 图片来自:NYTimes
极限“改造”狂潮背后,争议和伦理并生
去年,生物黑客圈就出了一件大事。
2018 年 4 月 29 日,生物黑客领域饱受争议的人物之一 Aaron Traywick 被发现死于华盛顿特区一家水疗中心。
而在他死亡 2 个月前,他才在媒体闪光灯的包围下,脱下裤子,给自己注射了一支 DIY 出来的、没有经过任何临床试验的疱疹治疗针剂。

这让一直在车库或地下室低调做实验的生物黑客,突然被提到舆论的风口浪尖。但当惨烈的后果暴露在闪光灯之下,人们也认为这只是一群狂妄的表演者而已。
尽管美国食品药品监督管理局(FDA)等机构强烈反对自我实验,但因为药物研发的监管规则并不能干涉个人对自身施加的行为,这些生物黑客也因此能够绕过监管,在他们自己身上测试产品。
他们处于合法的灰色地带。

▲Aaron Traywick。 图片来自:BBC
随着第三代基因编辑技术的普及,基因编辑成本变得越来越低,普通人很容易也能接触到最先进的生命科学技术。虽然生物黑客所制造的“超能力”,并不像弗兰肯斯坦的科学怪人那么戏剧化,但实验常常无法预料的结果,也让它不可避免地伴随着极大争议性。
去年 12 月,前 NASA 研究员 Josiah Zayner 在一次大会上给自己注射了基因编辑技术 CRISPR 的试剂。这个试剂能去除抑制肌肉的蛋白质,让他成为“绿巨人”。

▲ 图片来自:Natural Blaze
CRISPR-Cas9 被称为本世纪最大的生物技术发现之一,但实际上,一使用不当它就会产生致癌风险,且 FDA 明文禁止个人操作和出售 DIY 基因编辑包,更何况“基因编辑”这件事本就可怕到无人能料。
其实更多的,像 Traywick 创办的小型公司 Ascendance Biomedical,他们开展新基因治疗方案的研发和测试,目的只是希望治疗癌症、艾滋病,甚至抵抗衰老的方案。
第一个将未经测试的“实验基因疗法”注入腹部的人 Tristan Roberts,曾在 Facebook 直播了注射活动。6 年前 Roberts 被诊断为艾滋病,在没有药剂能治疗,他选择了尝试生物疗法。

▲图片来自:Twitter
当他掀开 T 恤把针头抬起准备插入时,猛吸了一口气:
我希望将这一切献给所有因为无法获得治疗而死亡的人。
他们很容易剑走偏锋,但同时,他们也正在创造新生。
Facebook 创办人朱克伯格(Mark Zuckerberg)和 Tesla 创办人马斯克(Elon Musk)都是生物黑客的支持者,马斯克认为“人类生物学和技术必须融合,才能让人类跟上技术进步。”

但大部分公众对这场运动的性质还是存在忧虑。
在 2016 年的一项调查中,69% 的美国人反对使用大脑芯片来提高认知能力,63% 的人反对通过用人工合成血液提高血液含氧量来使人变得更强壮、跑得更快。调查显示,人们普遍不相信这些增强手段会被以负责任和安全的方式使用。
许多科学家和生物伦理学家也认为,这样的实验太过业余且无法产生任何有意义的结果,自我实验的危险已经大于投机的好处,或者很多尝试的患者,可能根本不知道他们在做什么。

但实际上,生物黑客圈也有自己的一套准则。
他们大部分都是具备高科学素养的精英人士,遵循国家和地区的规定、合理处置废料垃圾、遵守安全细则、不使用病原体,否则就会被团体视为生物恐怖分子。
像 Traywick 那样在公众注视下无试验注射未经试验针管的所作所为,是生物黑客同行所不允许的范围。在这个分界口后,部分人也投身于向生物黑客群体强调 DIY 实验的安全性和谨慎性的宣传事业。
生物学家 Ellen Jorgensen 也在 Ted 的演讲中说到:“实验期间因为安全而发生的事故,就像一场暴雪降临在沙哈拉沙漠正中一样小,有可能发生但绝不值得过分担忧。”
如果你对合成生物学、纳米生物科技这种东西真正感兴趣,就请同时关注相关业余爱好群体和专业人士,因为专业人士他们有更好的基础设施和设备,也能直接让你接触病原体。

▲ Ellen Jorgensen
那么有人会问,为什么不直接选择在主流科学行业进行研究?
这也是生物黑客存在的原因所在:他们可以无需向任何权威解释想法,无须经过严格、昂贵、漫长的审查等待,无需考虑它的是否会带来丰厚利润,无须在意它是否是抱着拯救人类的名誉进行。。。。。。

▲ 《H+》超人类主义展览
只是任何强大的科技,生来都具有两面性。
个人电脑也是从实验室里应用和传播起来,而且如果没有开源的 Linux 和安卓系统,我们今天也就没了廉价而多样的智能手机。
个人生物科技作为一个全新领域正在崛起,只是媒体经常高估他们的技术能力,低估他们道德水准。
当你发现上面提到的人都没有提到他们“后来呢”,是的,他们后来或因为不守规则而死亡、或时而艰难时而美好地活着,但他们的命运和常人并无区别,只是多了一股撞南墙的勇气而已。

▲ 图片来自:idntimes
基于生物黑客,超越生物黑客
2012 年,在地下室、车库、创业空间和临时实验室,一群群 DIY 研究人员、科学家、程序员和神经学家在他们的生物黑客社区,一起研究可以用人类思想控制视频游戏的大脑界面。
这只是他们无数同样日子的平凡一日。
谁会猜到某个生物黑客某天就研发出了耳蜗植入物的仿生腿,在聋人能听到声音那天起,改变了一个人的世界?
而在不久的将来,他们还将引发新的商业繁荣。
当下针对人类本身增强的训练正在成为热潮,包括 DIY 机器人、间歇性禁食、量化自我、冥想改进等,这也是世界各地生物黑客的基本目标,如 Dave Asprey 的防弹养生咖啡或像 CureTogether 这样的众包健康项目。

▲ Twitter 和 Square 首席执行官 Dorsey 一直在尝试间歇性禁食
在纽约、波士顿、匹兹堡,很多生物黑客更加活跃。纽约 Biohackers NYC Meetup 小组以及数家初创公司、孵化器,开始集合更多力量并走向“正规化”,通过实验和科学创造市场上可行的控制论产品。
Biohackers NYC 集团创始人说过,他们的目的是涵盖人类从身体到心灵的生物范围,无论是技术还是营养方面,都让人们有潜力成为社会中最优的人,这就是生物黑客的意义所在。

▲ 图片来自:hackernoon
匹兹堡的 Grindhouse Wetwares 是一个基于互联网,集合了程序员、工程师和科学家的生物黑客集体。他们开展了用电流激活大脑、医学植入健康追踪、将人与机器合并等项目,致力于“使用安全、经济、开源的技术来增强人性”。
其实,Grindhouse 的商业模式跟早期的硅谷公司也很像——集体通过知识共享许可证提供项目计划,客户可以支付资助建造的设备,也可以在家里免费使用它们。

▲ Facebook 在 2017 年 4 月的 F8 开发者大会上透露,正开发脑机语言文本界面
而上文提到的“用脑波控制软件”,就是目前 DIY 控制论社区最繁荣的领域之一,脑机接口将越来越普遍,用户使用脑波读取最常见的游戏或简单应用,会成为未来常见的商业模式之一。
4 月 17 日《神经科学前沿》杂志最新一篇论文也指出,结合纳米技术、人工智能和其它传统的计算技术,未来几十年内“人脑 / 云接口”领域将出现突破性发展。

而这项技术现在已在货币化并大规模推向市场。
奥地利公司 g.tec 为患有运动障碍的患者发布了一种产品,让他们能使用脑波拼写单词。几年前也就有消费产品 MindWave Mobile 出现,人们在 Android 和 iOS 平台花 130 美元就可以通过脑波玩游戏(无需手动或手势输入)。
这也是将来技术和商业生态系统相连接,企业完成数字化转型和生存的代表性一面。

未来几十年后,当我们人手通过芯片植入就能通信和交流时,再回顾起今天,可能觉得现在我们依赖着让人失去方向和毁灭记忆的手机有点好笑;当我们回顾起生物黑客,可能就像现在回顾 70 年代早中期的硅谷或者 90 年代的斯坦福或哈佛大学那样——
一些科技爱好者和小商人在车库和宿舍里建造了自制电脑和软件,但后来他们成立了 Apple、Google 和 Facebook。

尽管现在这代生物黑客,大部分仍然还在默默无闻探索着人类和技术的渗透性边界。
但他们部分人或许已经超越肉体范围,用各异的能力和感官让自己的身体和精神都进入了一个更广的维度。
而这也是人类的未来最大可能之一:挣脱动物本体,从生物功能到机器增强,再到计算代码和算法功能的无缝转换,更深入地连接大脑、身体和自然世界。
那时候,我们或许会更懂得身而为人的真正独特所在。

▲图片来自:hackernoon
而他们正在做着的,或许就像电影《猜火车》里的主角那样,困局之中只好钻进一个黑不可测的马桶。不过谁也不知道从里面挣扎着游出去后能不能看见太阳。
反正不会比现在更糟,但探出头可能就是新世界。


